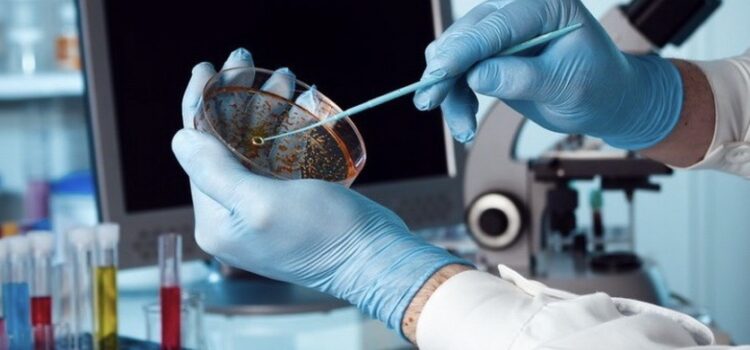

Министерство Здравоохранения Республики Казахстан

НАО «Медицинский университет Астана»

РОО «Общество врачей инфекционистов»
"Жаһандану жағдайындағы инфекциялық аурулар: туындалатын мәселелер және оларды шешу жолдары»
атты инфекционисттердің IV Халықаралық Конгресі
IV Международный Конгресс инфекционистов
«ИНФЕКЦИОННЫЕ БОЛЕЗНИ В УСЛОВИЯХ ГЛОБАЛИЗАЦИИ: НОВЫЕ ВЫЗОВЫ И РЕШЕНИЯ »
IV International Congress of Infectious Disease Specialists
“Infectious Diseases in the Era of Globalization: New Challenges and Solutions
Мероприятие завершено, Благодарим за участие!
Сертификаты слушателей доступны в личном кабинете!
9-10
октября
қазан
october
Radisson Hotel Astana
Целью Конгресса является обновление и пополнение знаний и обмен опытом в применении современных методов диагностики и терапии различных инфекций, эффективных подходов к противодействию глобальным угрозам, таким как пандемии, эмерджентные инфекции, антибиотикорезистентность, обсуждение взаимосвязи с урбанизацией и распространением инфекционных заболеваний, поиск решений по предотвращению новых эпидемий в условиях глобальных экологических изменений.
В рамках Конгресса будут проходить:
Пленарные заседания
Сателлитные симпозиумы, мастер-классы
Секция молодых ученых
Постерные доклады
Генеральный спонсор:

Главные спонсоры:



Основные спонсоры:



Спонсоры:



Участники:






9-10
октября
қазан
october
Место проведения:
Radisson Hotel Astana

Основные направления Конгресса: В рамках Конгресса будут обсуждены следующие ключевые вопросы:
1
Актуальные проблемы инфекционной патологии:
Анализ глобальных и региональных эпидемических процессов, современные стратегии противодействия, тенденции развития и прогностическая оценка.

2
Инновационные технологии в диагностике инфекционных заболеваний:
Cовременные методы лабораторных исследований, внедрение цифровых технологий и искусственного интеллекта в клинико-диагностическую практику.
3
Современные терапевтические подходы в лечении инфекционных заболеваний:
Новые стратегии и лекарственные средства, направленные на повышение эффективности противоинфекционной терапии.


4
Иммунопрофилактика и вакцинопрофилактика инфекционных заболеваний:
Новейшие достижения в разработке вакцин и их значение для обеспечения глобальной эпидемиологической безопасности.
Программа Конгресса предназначена для специалистов широкого круга - ППС медицинских университетов, врачей- инфекционистов, врачей общей практики, эпидемиологов, терапевтов, педиатров, врачей лабораторной диагностики, резидентов, магистрантов, докторантов, студентов медицинских вузов.
Спикеры Конгресса:

Акмарал Шарипбаевна Альназарова
Казахстан
Министр здравоохранения РК

Скендер Сыла
Казахстан
Руководитель странового офиса ВОЗ в Казахстане

Анар Акылбековна Турмухамбетова
Казахстан
Председатель правления, ректор НАО «Медицинский университет Астана» (Казахстан)

Сархат Сагинтаевна Бейсенова
Казахстан
Председатель Комитета санитарно-эпидемиологического контроля главный государственный санитарный врач РК (Казахстан)

Бахыт Нургалиевна Кошерова
Казахстан
Главный внештатный взрослый инфекционист ректор НАО «Карагандинский медицинский университет»

Динагуль Аяпбековна Баешева
Казахстан
Председатель Правления РОО «Общество врачей инфекционистов» заведующая кафедрой детских инфекционных болезней НАО МУА

Наталья Юрьевна Пшеничная
Россия
Заведующая кафедрой инфекционных болезней Российской медицинской академии непрерывного профессионального образования (РМАНПО), эксперта Всемирной организации здравоохранения (ВОЗ)

Николай Иванович Брико
Россия
Заведующий кафедрой эпидемиологии и доказательной медицины медико-профилактического факультета Первого МГМУ им. И. М. Сеченова. Главный внештатный эпидемиолог МЗ РФ

Susu Zughaier
Катар
Доцент кафедры микробиологии и иммунологии медицинского колледжа Катарского университета

Розалия Хасановна Бегайдарова
Казахстан
Доктор медицинских наук., профессор кафедры инфекционных болезней и фтизиатрии НАО МУК(Казахстан)

Галия Габдуллаевна Куттыкужанова
Казахстан
Доктор медицинских наук, профессор. Независимый эксперт РОО «Национальная Медицинская Ассоциация». Академик АН клинической и фундаментальной медицины Республики Казахстан. (Казахстан)

Амангуль Куандыковна Дуйсенова
Казахстан
Доктор медицинских наук, профессор, заведующая кафедрой инфекционных и тропических болезней НО КазНМУ им. С. Д. Асфендиярова

Галина Даутовна Жумагалиева
Казахстан
Кандидат медицинских наук, ассоциированный профессор кафедры детских инфекционных болезней НАО МУА

Манар Асыровна Смагул
Казахстан
Заместитель председателя правления РГП на ПХВ «Национальный центр общественного здравоохранения» МЗ РК

Ольга Александровна Бургасова
Россия
Профессор, заведующая лабораторией иммунопатогенеза инфекционных заболеваний РУДН

Юрий Станиславович Александрович
Россия
Доктор медицинских наук, профессор, заведующий кафедрой анестезиологии, реаниматологии и неотложной педиатрии ФП и ДПО Санкт-Петербургского ГПМУ, главный детский анестезиолог-реаниматолог Министерства здравоохранения РФ в Северо-Западном федеральном округе

Тамара Васильевна Косенкова
Россия
Доктор медицинских наук, профессор кафедры детских болезней с клиникой института медицинского образования «НМИЦ им В.А Алмазова» МЗ РФ г.Санкт-Петербург

Шолпан Адлгазыевна Кулжанова
Казахстан
Доктор медицинских наук, профессор, заведующая кафедрой инфекционных болезней и клинической эпидемиологии НАО «Медицинский университет Астана»

Гульмира Алкеновна Утепбергенова
Казахстан
Доктор медицинских наук, профессор кафедры инфекционных болезней и фтизиатрии МКТУ им. Х.А.Ясави, член-корреспондент РАЕ
ПРАВИЛА ПОДАЧИ УСТНОГО ДОКЛАДА:

Заявки на устные доклады следует направлять в Оргкомитет на адрес электронной почты: rooovi2@mail.ru, количество авторов — строго не более 3.
Продолжительность доклада не более 10 минут (доклад для секции молодых ученых – 7 минут).
Предоставление презентации доклада в формате PowerPoint, с расширением *ppt , *pptx.
Приоритет включения устных и постерных докладов в научную программу имеют члены РОО «Общества врачей инфекционистов».
Оргкомитет оставляет за собой право осуществлять отбор докладов для устного представления, а также при необходимости переводить их в формат стендовых (постерных) презентаций.
ПРАВИЛА ОФОРМЛЕНИЯ ПОСТЕРНОГО ДОКЛАДА:

Стендовые доклады представляются в виде видеопрезентации (формат MP4), продолжительностью не более 3 минут, с обязательным аудиосопровождением каждого слайда (при этом текст на слайдах должен быть минимизирова) в Оргкомитет на адрес электронной почты: rooovi2@mail.ru, количество авторов — строго не более 5.
Презентация должна быть выполнена в программе PowerPoint (или её аналоге) с белым фоном, чёрным шрифтом и использованием формата слайдов 16:9. Допускаются визуальные элементы: графики, таблицы и изображения.
По итогам проведения постерной сессии в интерактивном формате будут выбраны три лучших доклада, которым будут присуждены призовые места и поощрительные награды.
Рекомендуемые отели по категориям в г.Астана
Роскошные отели


Если вы предпочитаете роскошь и комфорт, в Астане есть несколько первоклассных отелей, таких как «The St. Regis Astanа», «Radisson Hotel Astana», «The Veil Hotel», «Hilton Astana», «Hilton Garden Inn Astana».
Эти отели предлагают превосходные условия включая, спа-центры, фитнес залы, рестораны высокой кухни и конференц-залы для деловых встреч.
Бизнес отели


Для тех кто приезжает с деловыми целями, идеальными вариантами станут «Park Inn by Radisson Astana», «Best Western Plus Astanа», «Elite Apart‑Hotel», «Marriott Hotel Astana», «Hampton by Hilton Triumphal Arch».
Бюджетные гостиницы


Если вы ищете более экономичные варианты, в Астане есть множество уютных и доступных гостиниц, таких как «Ibis Astana», «Altyn Adam Hotel», «East Astana Hotel», «Prestige Hotel», «Sky Lux Hotel», «Hotel San Marino».
Эти отелы предоставляют комфортные номера и все необходимые удобства по доступным ценам.
| Best Western Plus Astana | 13A Dostyk street, Astana, 010000 | Сайт: https://www.bestwestern.com/ +7 (7172) 27 79 99 | ~$85‑95 |
| Elite Apart‑Hotel | пр. Кошкарбаева 10/1, ЖК «Higvill», блок G, этаж-D6 | Сайт: https://eliteapart.kz/ru +7-707-727-7788 | ~$50‑80 |
| Marriott Hotel Astana | Улица Достык, 2 | Сайт: https://marriott-hotels.marriott.com/ru-RU/ +7 (7172) 62‒07‒70 | ~$40 |
| Hampton by Hilton Triumphal Arch | Mangilik El Avenue 43A, Astana 010000 | Сайт: https://www.hilton.com/ +7 7172 703 500 | ~$70‑90 |
| Altyn Adam Hotel | Улица Сакена Сейфуллина, 261-5 этаж | |
| East Astana Hotel | Улица Мухтара Ауэзова, 121-2 этаж | +7‒701‒144‒43‒97 +7 (7172) 33‒53‒35 |
| Prestige Hotel | Улица Желтоксан, 1 | +7 (7172) 32‒51‒81 +7‒771‒083‒80‒94 |
| Sky Lux Hotel | Проспект Женис, 43 | +7‒775‒681‒04‒89 |
| Hotel San Marino | Улица Жумабека Ташенова, 17Б | +7‒707‒808‒04‒33 |
| Ibis Astana | Юго-Восток (правая сторона) ж/м, Алматы район, Астана | +7 (7172) 70‒82‒00 |